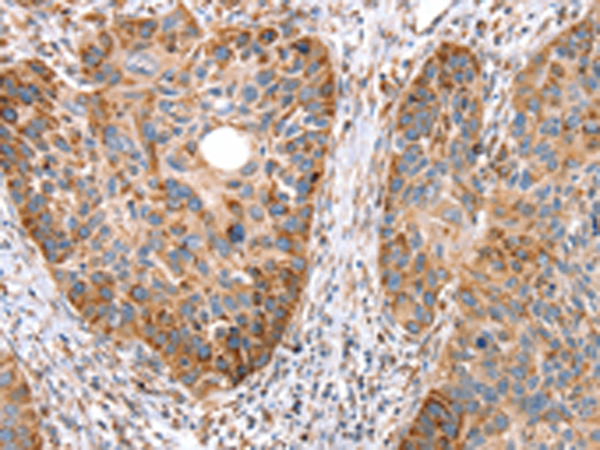
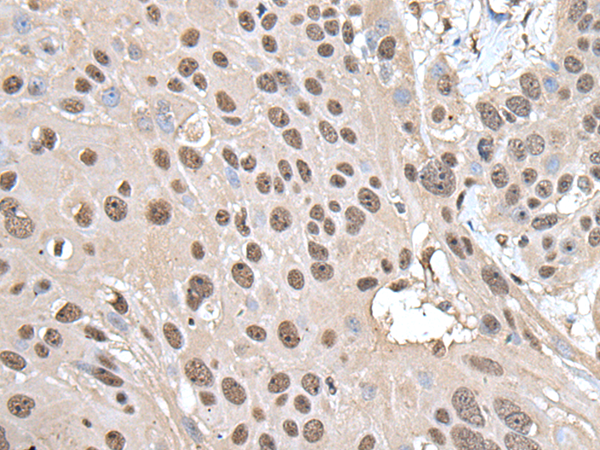
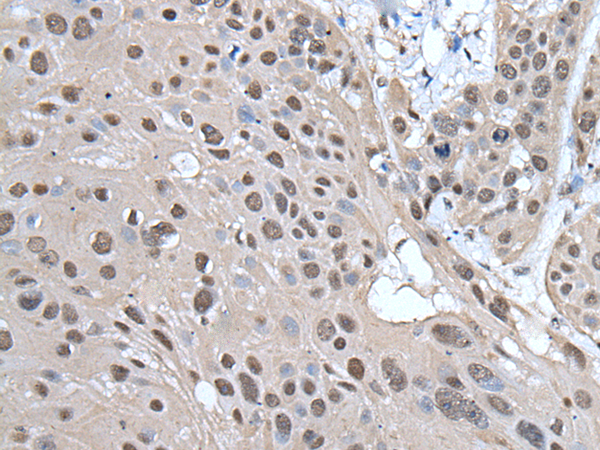

-
分类: 科研抗体货号: P01796别名: SHIP; SHIP1; SHIP-1; hp51CN; SIP-145; p150Ship应用: WB,IHC反应种属: Human
-
分类: 科研抗体货号: P01764别名: SA1; MRD47; SCC3A应用: WB,IHC反应种属: Human
-
分类: 科研抗体货号: P01840别名: SSBP; mtSSB; Mt-SSB; SOSS-B1应用: IHC反应种属: Human, Mouse, Rat
-
分类: 科研抗体货号: P01795别名: RAI; NSHC; SHCC; N-Shc应用: WB,IHC反应种属: Human, Mouse, Rat
-
分类: 科研抗体货号: P01817别名: SMC1; SMCB; CDLS2; SB1.8; SMC1L1; DXS423E; SMC1alpha应用: WB,IHC反应种属: Human, Mouse, Rat
-
分类: 科研抗体货号: P01839别名: SSA2; RORNP; TROVE2应用: IHC反应种属: Human, Mouse
-
分类: 科研抗体货号: P01794别名: HSB1; CIN85; GIG10; HSB-1; MIG18; CD2BP3应用: WB,IHC反应种属: Human, Mouse, Rat
-
分类: 科研抗体货号: P01816别名: LSH; PASG; SMARCA6; Nbla10143应用: WB,IHC反应种属: Human, Mouse
-
分类: 科研抗体货号: P01838别名: SSA; RO52; SSA1; RNF81; Ro/SSA应用: IHC反应种属: Human
-
分类: 科研抗体货号: P01793别名: SEST3应用: IHC反应种属: Human, Mouse

鄂公网安备42018502007531号
鄂公网安备42018502007531号

